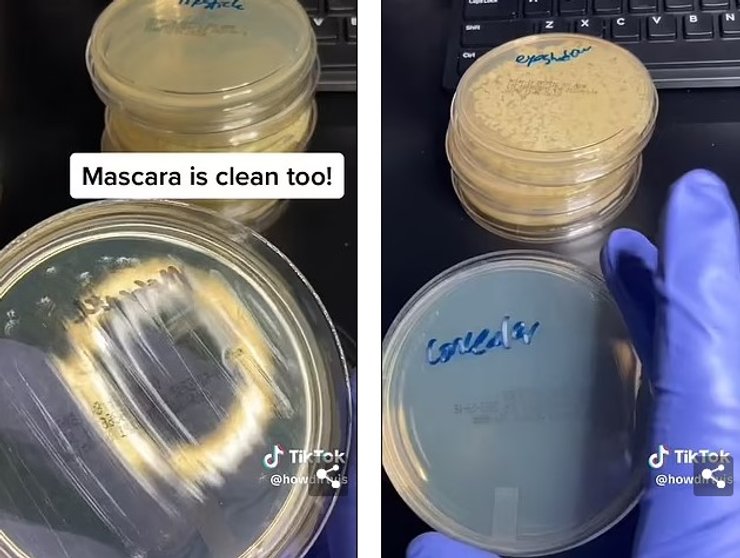
тушь образец

Инфекции костей и фекалии. Почему стоит держаться подальше от тестеров косметики в магазинах (фото)

В новом исследовании ученые взяли мазки губной помады, теней для век, консилера и туши для ресниц. То, что они увидели дальше, шокировало ученых.
Тестеры косметики в магазинах могут показаться весьма хорошей идеей — казалось бы, таким образом повышаются шансы подобрать продукт, который подходит именно вам. Однако исследователи считают, что это может быть чрезвычайно опасно для здоровья, пишет Daily Mail.
В ходе эксперимента мазки губной помады, румян, теней для век, консилеров, туши для ресниц и мультистиков были собраны с тестеров в одном из магазинов Sephora. Далее их поместили в чашке Петри и инкубировали в течение нескольких дней. Результаты исследования оказались удручающими.
У Фокус. Технологии появился свой Telegram-канал. Подписывайтесь, чтобы не пропускать самые свежие и захватывающие новости из мира науки!
Результаты исследования показывают, что образцы помады, туши и консилера оказались совершенно чистыми. Увы, про другие продукты такого не скажешь — образцы теней и мультистиков буквально кишели бактериями. Отметим, что магазины, как правило, предлагают специальные ватные палочки, подушечки или одноразовые аппликаторы, которые должны были бы предотвратить распространение бактерий. Однако покупатели часто используют пальцы и наносят косметику прямо на лицо.
Исследователи отмечают, что бактерии на образцах косметики, вероятно, разрастаются из-за того, что люди повторно наносят ватные палочки и подушечки на косметики, после того, как они уже коснулись кожи. Однако ученые предупреждают, что подобная халатность может привести к развитию стафилококковых инфекций, инфекций мочевыводящих путей, респираторных заболеваний и даже пневмонии.
По словам дерматолога Тами Бусс Кассис, на образцах косметики часто обнаруживаются бактерии и грибки стафилококка, которые являются основной причиной развития инфекций кожи и мягких тканей, а они могут привести к образованию фурункулов. Кассис советует максимально избегать тестеров и отдавать предпочтение новым продуктам. Если же избежать теста косметики не получится, следуйте простым правилам:
- убедитесь, что тестер запечатан;
- используйте одноразовый аппликатор;
- нанесите продукт на тыльную сторону ладони.
По информации Министерства здравоохранения Миннесоты, в большинстве случаев стафилококковые инфекции не являются серьезными, однако в некоторых случаях они могут обернуться серьезными проблемами, такими как:
- инфекции кровотока;
- пневмония;
- инфекции костей и суставов.
Отметим, что подобный эксперимент уже был проведен ранее в 2017 году. Тогда ученые исследовали образцы косметики из трех крупных магазинов. Образцы были проверены в сертифицированной микробиологической лаборатории, а результаты оказались крайне тревожными — все образцы дали положительный результат на золотистый стафилококк. Более того, на некоторых образцах и вовсе обнаружили бактерии из кишечного тракта. По словам нью-йоркского дерматолога Уитни Боу, нанося косметику с тестеров себе на кожу, вы буквально можете "наносить и размазывать чужие фекалии на свои губы".
Ранее Фокус писал о том, что ученые рассказали всю неприятную правду о купании в джакузи.